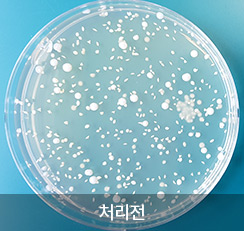
항균력 평가
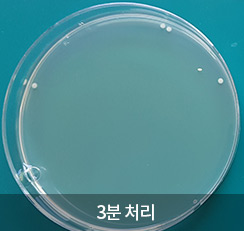
항균력 평가
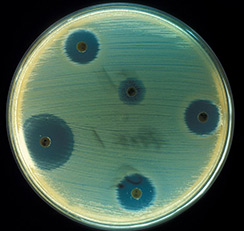
항균력 평가

항균력 평가
HOME > 시험 항목 > 항균력 평가
항균력 평가
항 미생물제제의 미생물에 대한 저항성을 측정하는 평가방법으로 MIC test, Paper Disc Method 등 다양한 시험 방법이 있습니다.

Candida albicans ATCC 10231에 대한
항균 효과
Paper disc diffusion 결과
(사진:위키피디아)
☞ 시험에 소요되는 기간과 시료 량은 시험 방법에 따라 차이가 있으므로 담당자와 협의하시기 바랍니다.
☞ 항균력 평가의 경우 영문 보고서는 추가 비용이 발생합니다.


